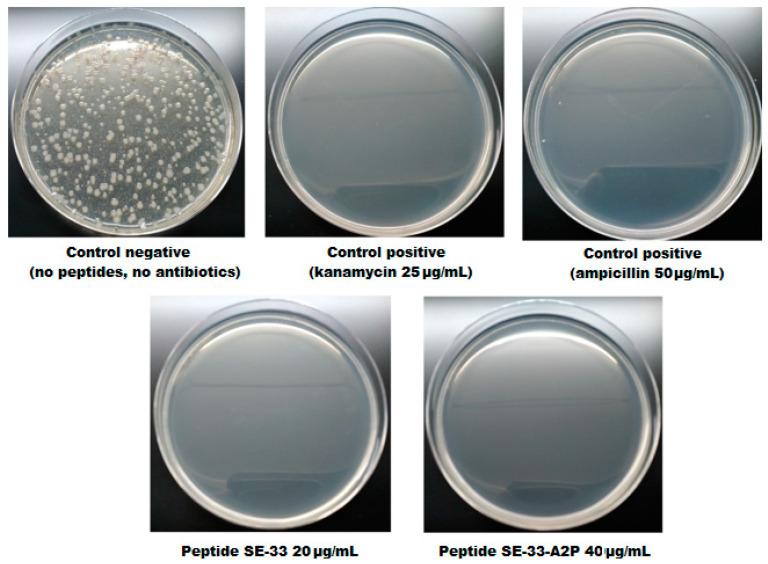
https://cdn.ncbi.nlm.nih.gov/pmc/blobs/d1e9/10886013/203de26b63c5/antibiotics-13-00190-g013.jpg

抗菌肽SE-33-A2P(一种经修饰的组织蛋白酶抗菌肽类似物)的表达及其特性分析
Expression of the Antimicrobial Peptide SE-33-A2P, a Modified Analog of Cathelicidin, and an Analysis of Its Properties.
作者信息
Gasanov Vagif, Vorotelyak Ekaterina, Vasiliev Andrey
机构信息
Laboratory of Cell Biology, N.K. Koltzov Institute of Developmental Biology of Russian Academy of Sciences, Vavilov Str. 26, 119334 Moscow, Russia.
出版信息
Antibiotics (Basel). 2024 Feb 16;13(2):190. doi: 10.3390/antibiotics13020190.
In this study, we developed a method for the expression of the antimicrobial peptide SE-33-A2P in bacterial cells. The SE-33-A2P peptide consists of A2P and SE-33 peptides and is a retro analog of cathelicidin possessing antimicrobial activity against both Gram-positive and Gram-negative bacteria. Furthermore, the A2P peptide is a self-cleaving peptide. For an efficient expression of the SE-33-A2P peptide, a gene encoding several repetitive sequences of the SE-33 peptide separated by A2P sequences was created. The gene was cloned into a plasmid, with which cells were transformed. An induction of the product expression was carried out by IPTG after the cell culture gained high density. The inducible expression product, due to the properties of the A2P peptide, was cleaved in the cell into SE-33-A2P peptides. As the next step, the SE-33-A2P peptide was purified using filtration and chromatography. Its activity against both Gram-positive and Gram-negative bacteria, including antibiotic-resistant bacteria, was proved. The developed approach for obtaining a prokaryotic system for the expression of a highly active antimicrobial peptide expands the opportunities for producing antimicrobial peptides via industrial methods.
在本研究中,我们开发了一种在细菌细胞中表达抗菌肽SE - 33 - A2P的方法。SE - 33 - A2P肽由A2P和SE - 33肽组成,是一种对革兰氏阳性菌和革兰氏阴性菌均具有抗菌活性的cathelicidin的反向类似物。此外,A2P肽是一种自切割肽。为了高效表达SE - 33 - A2P肽,构建了一个编码由A2P序列分隔的多个SE - 33肽重复序列的基因。该基因被克隆到质粒中,然后用其转化细胞。在细胞培养达到高密度后,通过IPTG诱导产物表达。由于A2P肽的特性,诱导表达产物在细胞内被切割成SE - 33 - A2P肽。下一步,使用过滤和色谱法纯化SE - 33 - A2P肽。已证明其对革兰氏阳性菌和革兰氏阴性菌(包括耐药菌)均具有活性。所开发的用于获得表达高活性抗菌肽的原核系统的方法,扩展了通过工业方法生产抗菌肽的机会。